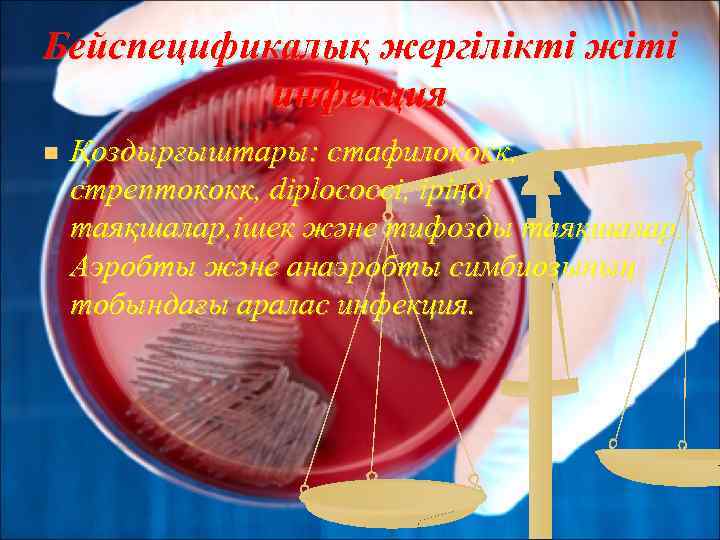
Бейспецификалық жергілікті жіті инфекция n Қоздырғыштары: стафилококк, стрептококк, diplococci, іріңді таяқшалар, ішек және тифозды

хир.през.ppt
- Количество слайдов: 18

«Интердент» медициналық колледжі Хирургиялық инфекция. Бейспецификалық хирургиялық жергілікті инфекция Пән: Хирургия Оқытушы: Жұпарбек Н. Ж. Дайындаған: Оразбай Бегзада

n Хирургиялық инфекция- іріңді пайда етуші микробтар ағзаға түсіп, хирургиялық емді қажет ететін инфекция.

Іріңді аурулардың алғашқы белгілері Қан құрамындағы ақуыз фракциясы өзгерістер; v дене температурасының көтерілуі ; v Эритроцитопения; v Лейкоцитоз; v Тәбет төмендеуі. v

Бейспецификалық жергілікті жіті инфекция n Қоздырғыштары: стафилококк, стрептококк, diplococci, іріңді таяқшалар, ішек және тифозды таяқшалар. Аэробты және анаэробты симбиозының тобындағы аралас инфекция.


Қоздырғыштар Алтын стафилакок Стрептококк

Диплококк Гонококк

Тері және теріасты жасушаларындағы іріңді аурулар n Фурункул : n n n Карбункул Гидраденит Абсцесс Флегмона Рожистое воспаление Аденофлегмона

Фурункул n Фурункул (furunculus), сыздауық – шаш фолликуласы, май бездері, айналасындағы майлы клетчаткалардың жедел іріңді қабынуы, фолликулитке қарағанда ауқымды болып келеді. Дененің түкті жерлерінде дамиды.

Сатылары n n n Инфильтрация ; Іріңді некроз; Рубцов

Карбункул (шиқан)-өте ауыр, жайылған, бірнеше шаш фолликуласы, терінің май бездері, теріасты майының қабынулары және қан тамырлары тромбозының салдарынан пайда болған ауқымды іріңді некроздық процесс Сатылары: n Инфильтрация n іріңді термоядролық.

Флегмона n Флегмона - (көне грекше: φλεγμονή — қабыну) — дәнекер тінде болатын қабыну. Көбінесе, тері астындағы, алақан, табан, мойын, жамбас қуысында, т. б. жерлерде орналасқан майлы және дәнекер тіндерді зақымдайды. Флегмонаның бітеу жарадан айырмашылығы іріңді қабынудың басқа аймақтардан (тіндерден) шектейтін анық шекарасы болмайды

Рожа n Тілме (рожа) - гемолитикалық стрепококкпен шақырылатын, жедел және созылмалы түрлерінде өтетін, клиникасында қызбамен, интоксикациямен және терінің серозды немесе серозды-геморрагиялық ошақты қабынымен көрінетін антропонозды бактериальды инфекция.

Сатылары n Бастапқы кезеңі; n Ауыр, күшейген; n Айығу.

Емі n n n Антибактериальды терапия: жартылай синтетикалық пенициллины (ампициллин по 2 — 4 г тәул. ). Қосымша сульфаниламидты препарат (эритромицин, стрептоцид, сульфадиметоксин, сульфален). Дезинтоксикациондық терапия: Алғашқы 4 -5 күн аралығында. Көктамырға енгізу(тәулігіне 1, 5 -2 литр) инфузиялық және ауыр жағдайларда, қан алмастырғыштар және есірткі қан детоксикация қолданылады. УЗД

хир.през.ppt